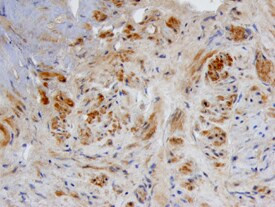
BMP-3 Antibody in Immunohistochemistry (Paraffin) (IHC (P))

Search
Invitrogen
BMP-3 Polyclonal Antibody
{{$productOrderCtrl.translations['antibody.pdp.commerceCard.promotion.promotions']}}
{{$productOrderCtrl.translations['antibody.pdp.commerceCard.promotion.viewpromo']}}
{{$productOrderCtrl.translations['antibody.pdp.commerceCard.promotion.promocode']}}: {{promo.promoCode}} {{promo.promoTitle}} {{promo.promoDescription}}. {{$productOrderCtrl.translations['antibody.pdp.commerceCard.promotion.learnmore']}}
图: 1 / 1
BMP-3 Antibody (PA5-47986) in IHC (P)

产品信息
PA5-47986
种属反应
宿主/亚型
分类
类型
抗原
偶联物
形式
浓度
规格
纯化类型
保存液
内含物
保存条件
运输条件
RRID
产品详细信息
In direct ELISAs, less than 1% cross-reactivity with recombinant human (rh) BMP-2, rhBMP-4, rhBMP-5, rhBMP-6, and rhBMP-7 is observed. This antibody very weakly recognizes native dimeric BMP-3.
Reconstitute at 0.2 mg/mL in sterile PBS.
Endoxin level is <0.10 EU per 1 µg of the antibody by the LAL method.
靶标信息
The BMPs belong to the TGF-Beta superfamilyBMPs stimulate the production of bone matrix proteins and thereby alter stromal cell and osteoclast proliferation, a key step in bone marrow development. In addition to promoting ectopic bone and cartilage development, BMPs regulate the growth, differentiation, chemotaxis, proliferation, and apoptosis of various cell types, including mesenchymal cells, epithelial cells, hematopoietic cells, and neuronal cells. BMPs also play a role in dorsal/ventral patterning. BMP3, highly expressed in lung, ovary and small intestine, participates in cartilage and bone formation. BMP3 and BMP2 genes map to conserved regions between human and mouse.
仅用于科研。不用于诊断过程。未经明确授权不得转售。
篇参考文献 (0)
生物信息学
蛋白别名: BMP; BMP-3; BMP-3A; Bone morphogenetic protein; bone morphogenetic protein 2A; Bone morphogenetic protein 3; bone morphogenetic protein 3 (osteogenic); Bone morphogenetic protein 3A; Osteogenin
基因别名: BMP-3A; BMP3; BMP3A
UniProt ID: (Human) P12645
Entrez Gene ID: (Human) 651